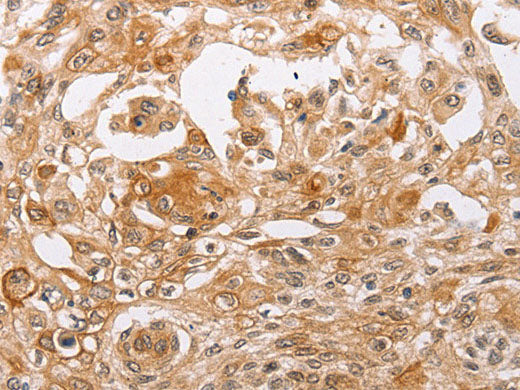
PPP1CB Polyclonal Antibody Store at -20°C
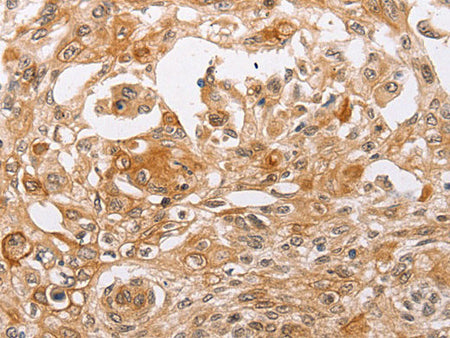
PPP1CB Polyclonal Antibody Store at -20°C

PPP1CB Polyclonal Antibody Store at -20°C
Couldn't load pickup availability

Still have questions? Ask our experts!
PPP1CB Polyclonal Antibody Store at -20°C
| SKU # | E-AB-10548 |
| Reactivity | Human, Mouse, Rat |
| Host | Rabbit |
| Applications | WB, IHC |
Product Details
| Isotype | IgG |
| Host | Rabbit |
| Reactivity | Human, Mouse, Rat |
| Applications | WB, IHC |
| Clonality | Polyclonal |
| Immunogen | Recombinant protein of human PPP1CB |
| Abbre | PPP1CB |
| Synonyms | MGC3672, PP 1B, PP-1B, PP1B, PP1beta, PPP1CB, PPP1CD, Protein phosphatase 1, Protein phosphatase 1 beta, Protein phosphatase 1 catalytic subunit beta isoform, Protein phosphatase 1 delta, beta isozyme, catalytic subunit, de |
| Swissprot | |
| Calculated MW | 37 kDa |
| Cellular Localization | Cytoplasm. Nucleus. Nucleus, nucleoplasm. Nucleus, nucleolus. Highly mobile in cells and can be relocalized through interaction with targeting subunits. In the presence of PPP1R8 relocalizes from the nucleus to nuclear speckles. |
| Concentration | 0.3 mg/mL |
| Buffer | Phosphate buffered solution, pH 7.4, containing 0.05% stabilizer and 50% glycerol. |
| Purification Method | Affinity purification |
| Research Areas | Cancer, Metabolism, Signal Transduction |
| Conjugation | Unconjugated |
| Storage | Store at -20°C Valid for 12 months. Avoid freeze / thaw cycles. |
| Shipping | The product is shipped with ice pack,upon receipt,store it immediately at the temperature recommended. |
Related Reagents
| Applications | Recommended Dilution |
| WB | 1:500-1:2000 |
| IHC | 1:25-1:100 |
Background
The protein encoded by this gene is one of the three catalytic subunits of protein phosphatase 1 (PP1). PP1 is a serine/threonine specific protein phosphatase known to be involved in the regulation of a variety of cellular processes, such as cell division, glycogen metabolism, muscle contractility, protein synthesis, and HIV-1 viral transcription. Mouse studies suggest that PP1 functions as a suppressor of learning and memory. Two alternatively spliced transcript variants encoding distinct isoforms have been observed.